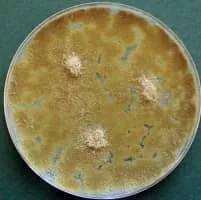

Paecilomyces
| Use attributes for filter ! | |
| Scientific name | Paecilomyces |
|---|---|
| Order | Eurotiales |
| Rank | Genus |
| Higher classification | Trichocomaceae |
| Class | Eurotiomycetes |
| Phylum | Ascomycota |
| Date of Reg. | |
| Date of Upd. | |
| ID | 1655043 |
About Paecilomyces
Paecilomyces is a genus of fungi. A number of species in this genus are plant pathogens. Several of the entomopathogenic species, such as "Paecilomyces fumosoroseus" have now been placed in the genus Isaria: in the order Hypocreales and family Cordycipitaceae. In 1974, R. A.